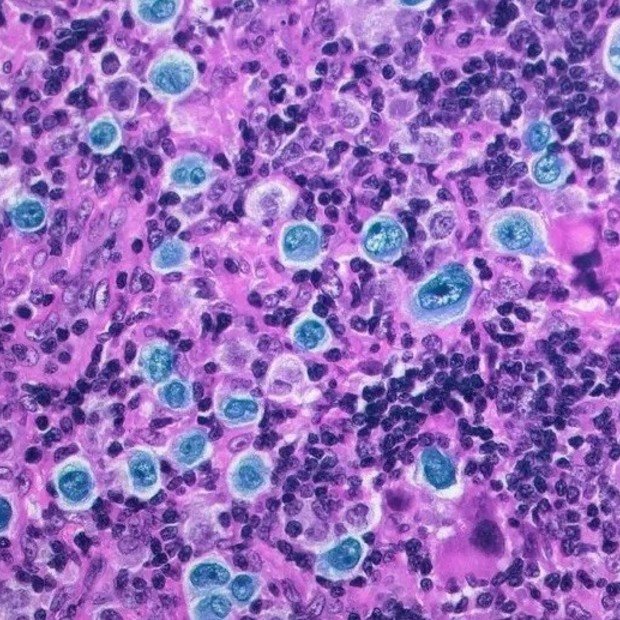
ISRAEL REPORTÓ REMISIÓN COMPLETA EN UN TRATAMIENTO PARA UN TIPO DE CÁNCER AVANZADO

Un estudio realizado en 15 centros de salud mostró que el 95% de los pacientes tratados logró remisión total con un nuevo esquema terapéutico, incluso en estadios avanzados, con una supervivencia

🤩Dragon's mom
@bvarina
AMOR VINCIT OMNIA... Ivo's mom! nothing will work unless you do!
ID: 1977235598
21-10-2013 03:11:21
34,34K Tweet
561 Takipçi
763 Takip Edilen




Un día después del triunfo del PRD, Héctor Brands reacomodó la sociedad que acumuló millonarios contratos con el Estado prensa.com/politica/un-di… vía La Prensa Panamá